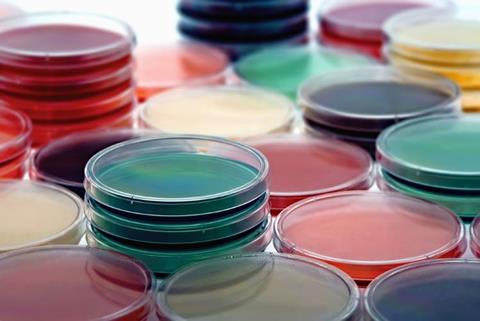
Image

The new sterilisation method could provide an affordable, rapid approach for preparing microbiological culture media, research suggests.
Research by Terrones-Fernandez et al. has demonstrated a simple, novel system for preparing microbiological culture media, and consequently, development of a new sterilisation method.
To evaluate the new sterilisation system, the researchers compared the microbiological properties of media prepared in a microwave (for different exposure times) with those of autoclaved sterilised media.
The authors noted that to date, “few studies have explored the utility of microwaves to prepare culture media from dehydrated ingredients in comparison with autoclaves.”
Autoclaving has limitations, such as high energy and equipment costs, long cycles, and it requires “considerable” space in the laboratory, according to Terrones-Fernandez et al.
The sterilisation method
The new system offers a rapid and cost-effective way to sterilise microbiological media and results in a “quality similar to that obtained through autoclaving"
The new system offers a rapid and cost-effective way to sterilise microbiological media and results in a “quality similar to that obtained through autoclaving.”
The authors summarised that “common media prepared in a microwave, equipped with a polycarbonate water bath and the use of a bottle with rehydrated media, a perforable rubber cap, and a sticker, were sterile after an exposure time of seven minutes [at a power of 1000 W] and had comparable or better microbiological properties than autoclaved media.”
Comparatively, the entire sterilisation process in the autoclave can take “up to 1.5 hours” according to the authors.
Based on “the growth of an important number of species in media exposed to a microwave, in comparison to the same autoclaved media, we can suggest that these conditions are softer than the autoclaving conditions and, thus, less degradation of nutrients and less generation of toxic compounds, such as reactive oxygen species (ROS), would occur under this microwave treatment,” the authors concluded.
Further observations
The paper also reported that the whole sterilisation process via microwaving also facilitated quicker gas elimination.
Terrones-Fernandez et al. noted microwave exposure for seven minutes resulted in sterile tryptone soy agar (TSA) plates.
Additionally, the paper highlighted that the lower growth of Pseudomonas aeruginosa detected in the microwave media could be advantageous for manufacturing certain selective media, in which the inhibition of Pseudomonas is often challenging.
The researchers established that a 10-minute exposure time rendered the best microbial growth results for S. ser. Typhimurium, E. coli ATCC 25922, and P. aeruginosa.
Several factors, “particularly exposure times and safety issues” must be considered to establish a new method for sterilising culture media, mainly because “microwaves are not specifically designed for this purpose”.
However, the system proposed in the study “could serve as a basis for developing a more affordable and rapid method to prepare culture media in routine laboratory practices.”
The paper was published in Applied Sciences.


